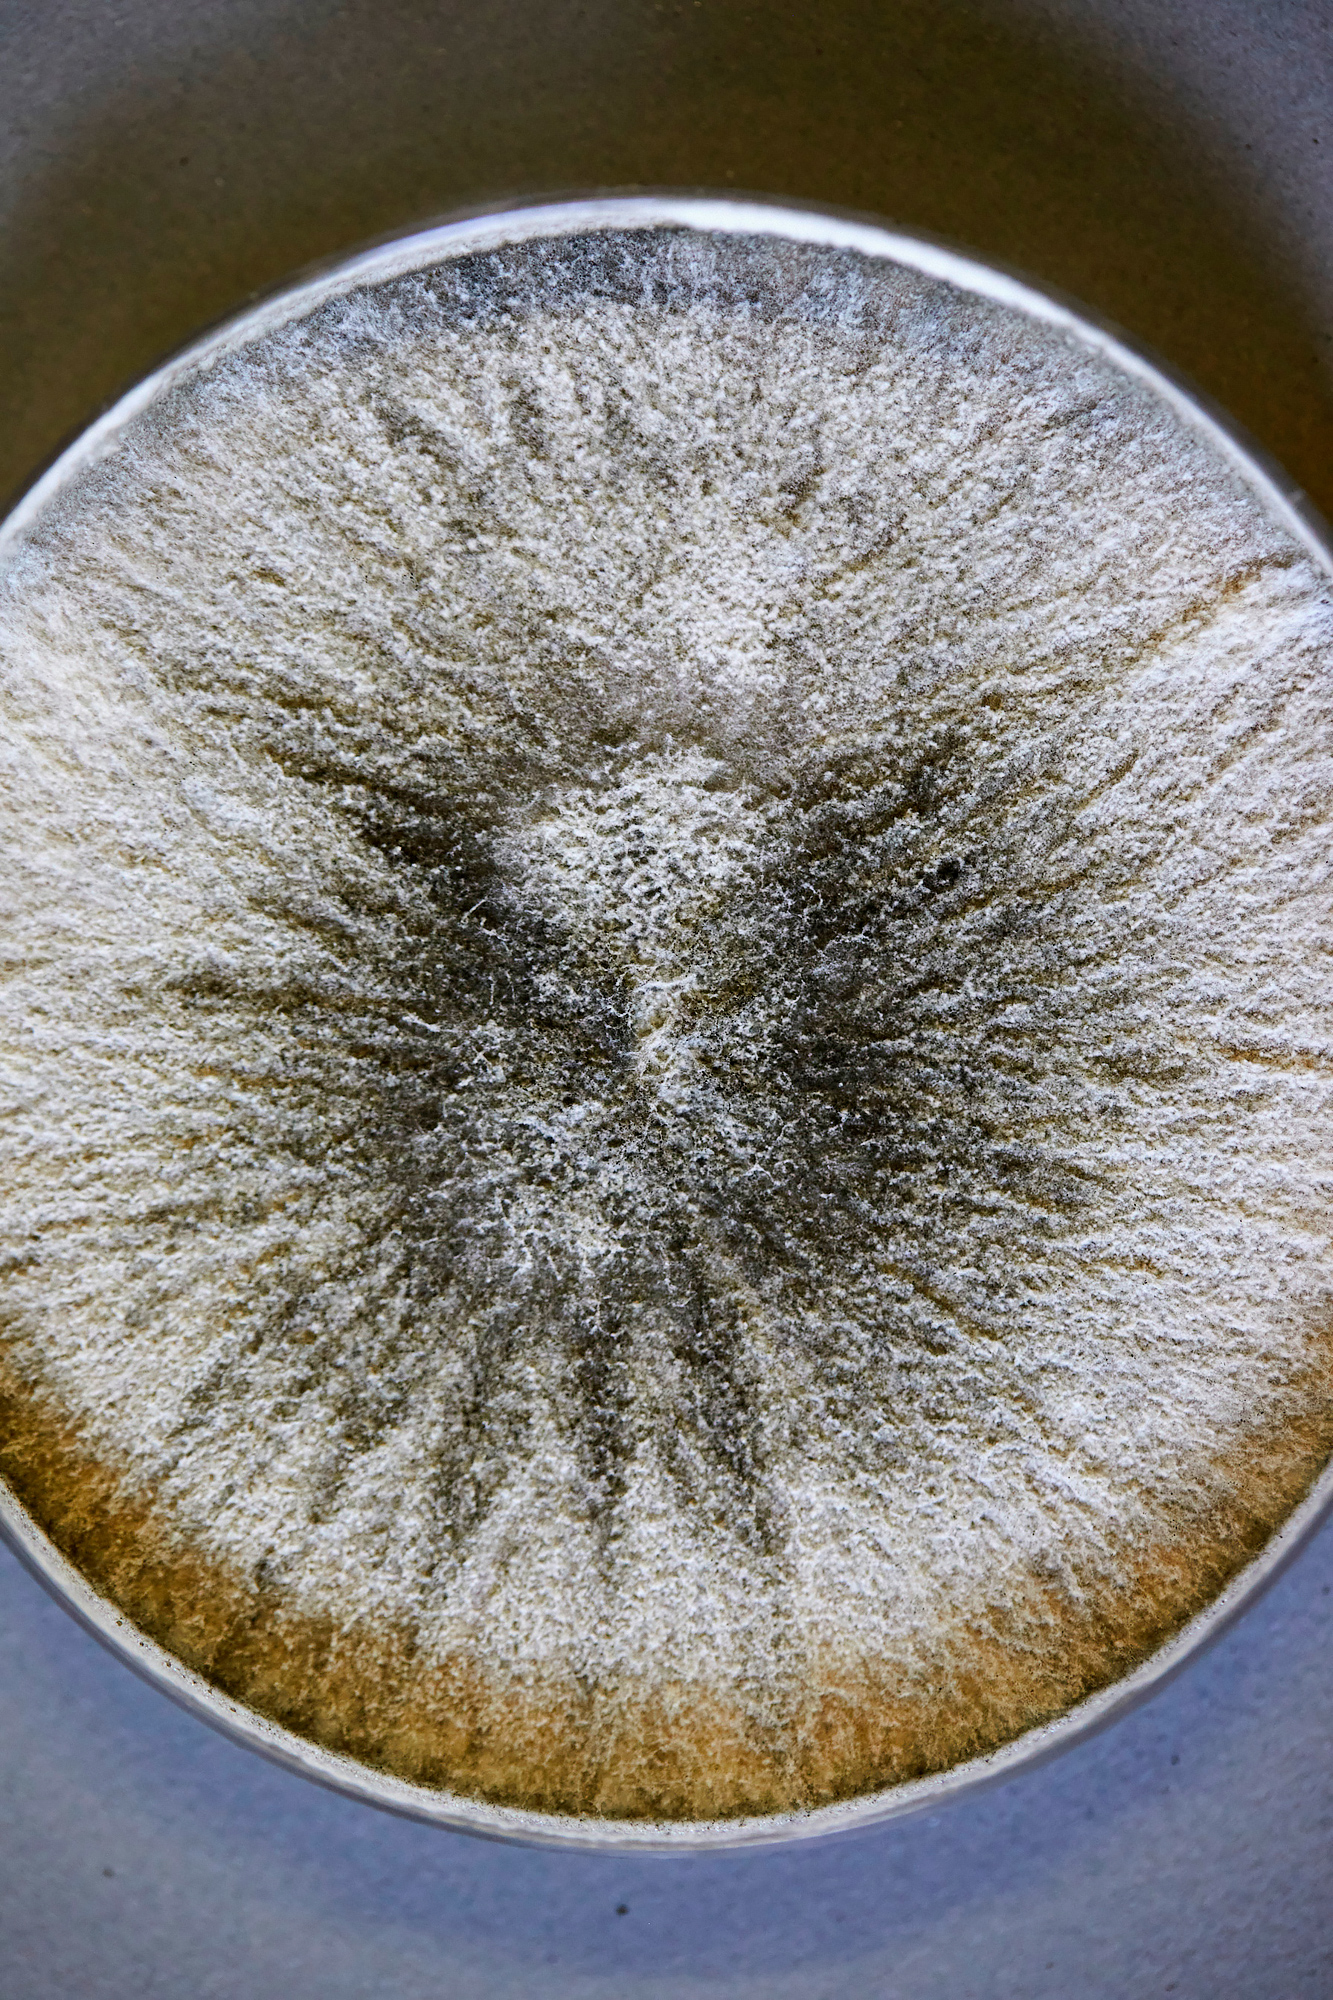

Bäckermeister Ludovic Gerboin beim schreddern

von alten Brotresten
„Wir können den herkömmlichen Anbau von Ölsaaten mit riesigen Monokulturen ersetzen durch eine abfall- freie, zirkuläre Bioökonomie"
600000 Tonnen Backwaren bleiben in Deutschland jedes Jahr übrig. Hefeöl aus Brotresten kann den Kreislauf schliessen.
Bildredaktion: Kristin Schütte
Text: Julia Graven

im Labor an der TU München
Hefepilz

Thomas Brück und ein Kollege

Zutaten zur Herstellung von Öl aus Brotresten

im Labor

fertiges Öl

Gerboin beim Krapfen backen